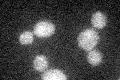
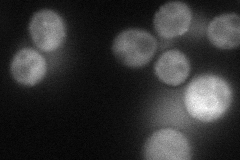
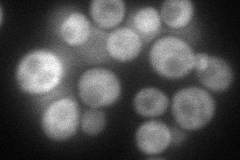
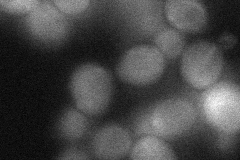
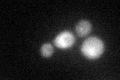
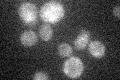

View description
Protein involved in the regulation of endocytosis; transiently recruited to actin cortical patches in a SLA1-dependent manner after late coat component assembly; GFP-fusion protein localizes to the periphery, cytoplasm, bud, and bud neck
Localization:
Intensity:
Fold change:
Significance:
-
C’ GFP library in SD
cytosol21.9 -
N' NOP1pr-GFP in SD
punctate,bud neck58.4531 -
N' TEF2pr-mCherry in SD
cytosol,punctate73.9904 -
N' NATIVEpr-GFP in SD

below threshold13.8658 -
N' TEF2pr-VC and Cyto-VN in SD
cytosol37.4392 -
C’ GFP library in SD+DTT
cytosol29.041.32Yes -
C’ GFP library in SD+H2O2

cytosol24.011.09No -
C’ GFP library in Starvation Media
cytosol18.150.82No -
C’ GFP library on the background of Pup2-DaMP

cytosol -
C’ GFP library on the background of CCT mutant

cytosol27.18711.24122No
